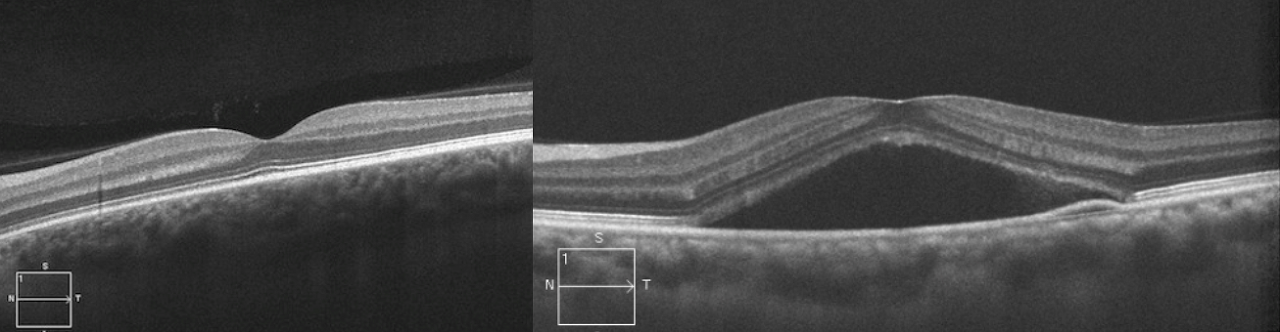

중심장액맥락망막병증은 망막의 중심부에 국한된, 경계가 분명한 장액성 감각신경망막박리 또는 망막색소상피박리가 나타나는 질환입니다. 남자가 여자보다 3~8배 정도 많고 대개 30~50대까지의 건강한 청장년층에서 많이 발생합니다. 주로 중심시력을 담당하는 황반에서 발생하므로 대부분 시력감퇴, 중심암점, 변시증, 소시증, 색각이상 등의 증상을 호소하게 됩니다.

원인
대부분 특별한 원인질환을 찾을 수 없는 특발성으로 발생하지만 큰 스트레스, 피로, 전신 스테로이드 치료, 임신, 말기신부전, 장기이식, 흡연, 음주, 치료되지 않은 고혈압 등과 연관 있는 것으로 알려져 있습니다. 병변 부위의 맥락막 혈관 이상이 중요한 기전으로 여겨지고 있습니다.
치료
유병기간에 따라 3~6개월 이내에 저절로 좋아지는 급성, 6개월 이상 지속되는 만성, 잦은 발생 및 호전을 반복하는 재발성 만성형으로 나눌 수 있습니다.
급성인 경우 매우 좋은 시력예후를 가지고 있고 보통 90%에서 치료 없이도 12주 이내에 저절로 호전되지만 시력회복은 12개월까지 천천히 회복되기도 합니다. 5%의 경우 심한 시력손상을 동반할 수 있으므로 3개월 이상 박리가 지속될 경우 치료를 고려할 수 있습니다. 광역학치료는 혈관으로 광민감물질을 주입한 후 이상 혈관에 도달했을 때 광민감물질에만 반응하는 특수한 레이저를 조사하여 선택적으로 이상혈관을 치료하는 방법입니다. 이 외에도 국소레이저 치료, 안구내 약물주입술 등을 시도해볼 수 있습니다. 그러나 자연 호전 또는 치료 후에도 재발하는 경우가 잦으며 만성형 또는 재발성 만성형으로 발전하는 경우 시세포의 손상, 망막하 섬유소 침착, 위축화, 황반변성이 동반되어 시력회복이 어려울 수 있습니다. 그러므로 스트레스를 받지 않고 피로하지 않도록 생활환경 개선이 가장 중요하고, 스테로이드 계 약물 복용 중단, 금연 및 금주가 도움이 됩니다.